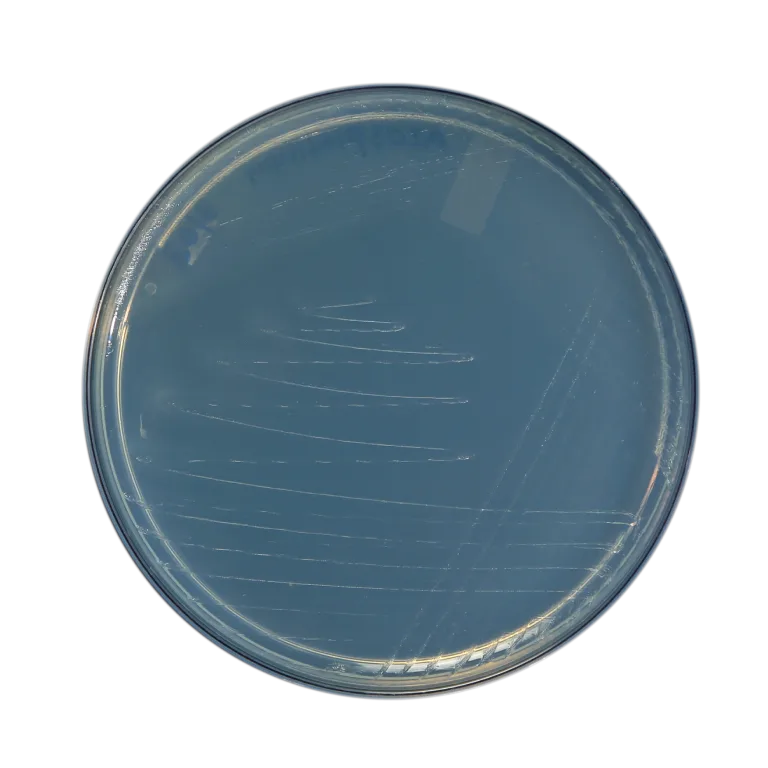
product

Talc Base Bio Fertilizer Powder

Azotobacter
Azotobacter are independent bacteria that can convert atmospheric nitrogen into…
Learn More
Azospirillum
A free-living nitrogen-fixing bacterium closely linked to grasses. Azospirillum bacteria…
Learn More

Phosphate Solubilizing Bacteria
Phosphorus ranks second only to nitrogen among mineral nutrients most…
Learn More
Potassium Mobilizing Bacteria
This microbe aids in releasing the immobile type of potassium…
Learn More

Zinc Solubilizing Bacteria
It solubilizes zinc through different methods, one of which is…
Learn More
Phosphate Solubilizing Fungal
They are a collective of helpful microorganisms capable of breaking…
Learn More
Sulphur Oxidizing Bacteria
Sulphur oxidizers participate in the conversion of elemental Sulphur into…
Learn More

